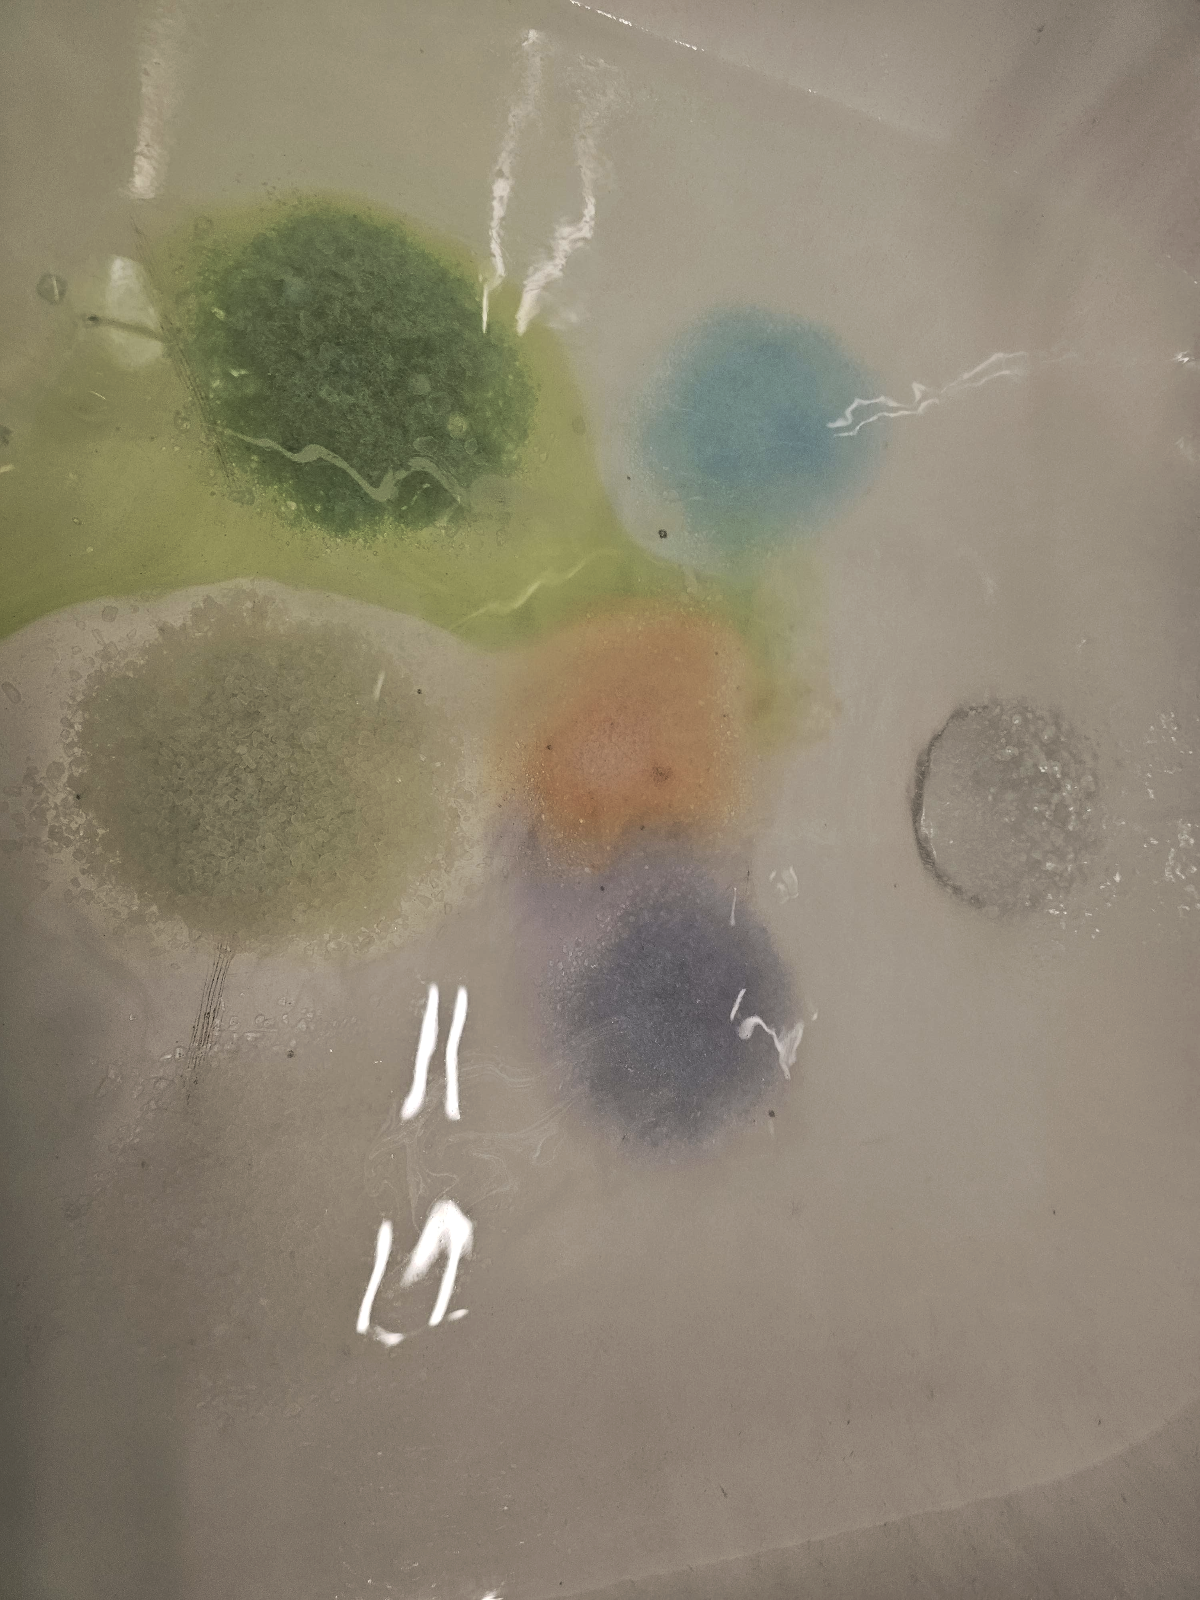
3a5b9a9f-fd63-49d3-8405-c39a71bbeb0b

To jest doprawdy zastanawiające jakim cudem hejto w firefoxie powoduje driver timeouty w radeonie jak się gra.
W diablo były 100% powtarzalności ale patch naprawił, ale w innych grach randomowo dalej wyskakują...
Co Wy kodzicie.
#hmmmmmmmmmmmm #hejto

Społeczność
szalone wpisy zielonego żelka
Zaloguj się aby komentować
Uhhhhh, po odświeżeniu hejto samo się wideo wznowiło 30 wpisów niżej...
Już dawno się to nie stało..
#ehhhhhhhhhhhhhhhhhh #hejtobugi #hejto
@Acrivec jakim cudem???? a może to video z reklamy a nie z wpisu?
@kris z wpisu który wcześniej odtwarzałem.
Zaloguj się aby komentować
@Acrivec Wincyj!
@Acrivec - zapodajesz hiciory żelek!
Zaloguj się aby komentować
@Acrivec pamiętam jak katowałem ten kawalek jadąc na Korsykę
Zaloguj się aby komentować
@Acrivec - dobre rzeczy żelek zapodajesz
Zaloguj się aby komentować
ale dawno tego nie słyszałem
chyba nawet w radio przestali to puszczać
Zaloguj się aby komentować
@Acrivec mi się podoba wykonanie nouvelle vauge
@Acrivec Pozdro Żelku!
Chciałbym taką Fiestę
Zaloguj się aby komentować
Odchamić się czas zacząć. Chamy.
#spotify #spotifywrapped #ehhhhhhhhhhhhhhhhhh

Xddd a jaki wiek ci przypisalo ? 180 lat?
@ErwinoRommelo 51
Zaloguj się aby komentować
@Acrivec wyglada jak kolonia bakterii
@Acrivec wyjdzie brąz
@InstytutKonserwacjiMaryliRodowicz wyszedł zielony
Halynę widzę w tym tęczu

Zaloguj się aby komentować
Chyba w wyniku moich zgłoszeń do UKE oraz PUODO pewien sklep internetowy miał kontrolę przeprowadzoną, bo mi dali rabat 90% na następne zakupy, do 400zł.
A wystarczyło nie stroszyć piórek i samemu sprawdzić czy system poprawnie działa i dostosować się do moich żądań usunięcia danych wg. RODO oraz sprzeciwu kontaktu marketingowego. Huh.
#wpiszdupy #hmmmmmmmmmmmm
I bardzo dobrze, ostatnio też dostałem mailing na maila podpiętego do allegro, to ładnie im zwróciłem uwagę żeby przemyśleli jeszcze raz te wysyłkę, bo przy następnej pójdzie już procedura zgłoszenia niezamówionego newslettera. Do tej pory cisza.
Zaloguj się aby komentować
Od odinstalowania apki w sumie zapominam że ten portal istnieje.
#wpiszdupy #hmmmmmmmmmmmm
@Acrivec - to gdzie się teraz chwalisz swoimi kąpielami?
Zaloguj się aby komentować
18+
Treść dla dorosłych lub kontrowersyjna
Ale dużo contentu na #wykop

@Acrivec ciemność widzę ciemnosć
@Umypaszka śniłaś mi się. Że do szkoły chodziliśmy na piechotę przez miasto bo było szybciej niż autobusem i siedziałaś w jednej klasie rok czy dwa xd
@TyGrySSek widzisz, Bozia pokarała za wyśmiewanie moich wpisów xd
Zaloguj się aby komentować
#grafika3d #blender
5 minut na 50% 1080p, myślałem że będzie lepsza wydajność na nowej karcie, hmmmm.

@Acrivec - a jaka to ta nowa karta?
@koszotorobur ta co była.
@Acrivec - no to czas na tą co będzie
Zaloguj się aby komentować
#citiesskylines2 #citiesskylines Colossal Order i Paradox się rozstają xD

@Acrivec O kurde. Patrząc po stanie skylines 2, wcale się nie dziwię. Pytanie kto bardziej zawinił. Developer czy paradox
@Jarem wystarczylo zebac w paczke wszystkie najlepsze mody z 1 i wrzucic to jako 2 ale nie ale po co, przeciez wiadomo, ze gracze wola mega grafike i 12fps xD wystarczylo zrobic stabilna gre w oparciu o najbardziej popularne mody
@100mph Ale musisz przyznać, że robienie skrzyżowań w dwójce jest dużo lepsze niż kwadraciaki z jedynki. Mam na myśli dołączanie jednego pasa itp.
Co nie zmienia faktu, że po odpaleniu dwójki, zrobiłem kilka dróg, gra chodziła jakbym miał 100k mieszkańców i złożyłem wniosek o zwrot xD
Zaloguj się aby komentować
Dzisiaj zaskakująco krótko!
#hejto

@Acrivec - @kris ja mam dokładnie tak samo - dzieje się tak od momentu updejtu gdzie daje nieprzeczytane powiadomienia na górę
@koszotorobur oj mi dłużej
Zaloguj się aby komentować
No fajny błąd xD
#hejto #hejtobugi

xD pomocny na równi z 'Coś poszło nie tak'
@Acrivec równoznaczne z

@Acrivec

Zaloguj się aby komentować
Zamiast pełnej kalibracji ręcznej przez displaycala zrobiłem najpierw automatyczną kalibrację hardwarową monitora (która jest na nim zapisywana), a potem displaycalem zrobiłem tylko profilowanie do tego co tam było.
Efekty są :O
tylko 0.27 średnia deltae.
Whitepoint pokazuje off bo monitor był kalibrowany pod 6500k a nie 6300k, mogłem weryfikacje ustawić na 6500k lul
#kolory #kolorymetr #monitory

Zaloguj się aby komentować
kuhwa ileż można, GIŃ NĘDZNY BANNERZE
#hejto #ehhhhhhhhhhhhhhhhhh

Wściekł się 🤬
Zaloguj się aby komentować
W końcu nastał czas mojej żarówki z ikeły. Świeciła się codziennie kilka-kilkanaście godzin. Kupiona chyba z 10 lat temu albo lepiej.
#hmmmmmmmmmmmm #ikea #żarówki #gorzkiezale
niech jej ziemia lepkim będzin
Zaloguj się aby komentować